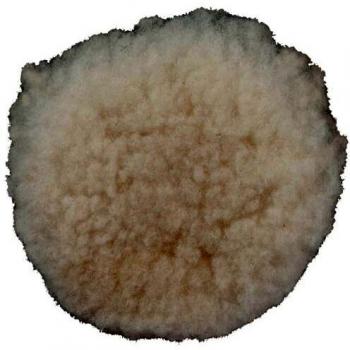
Metabo 631223000 Haft-Lammfellpolierscheibe 130 mm

Polierset 10tlg. PROFI Osborn
41.99 EUR
Festool Interface-Pad IP-STF
13.65 EUR
5 Polierfilze 128 mm Weich
27.99 EUR
Makita Polierwalze 794381‑9
182.37 EUR
Bosch DIY Polierschwamm Ø 125 mm
8.50 EUR
Metabo Polierschwamm 160 mm
20.90 EUR
Metabo Haftpolierfilz weich 130x5 mm
14.41 EUR